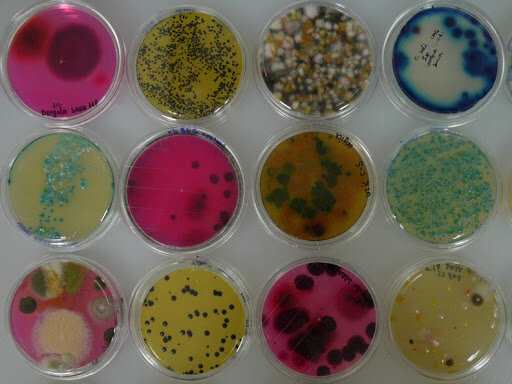
Otros logros de koch

-
 Libro Micrographia, el primer libro dedicado a las observaciones microscópicas, Hooke ilustró los
Libro Micrographia, el primer libro dedicado a las observaciones microscópicas, Hooke ilustró los
cuerpos fructificantes de los mohos. Fue la primera
descripción conocida de un microorganismo. -
 El primero que observó las bacterias, las células microbianas
El primero que observó las bacterias, las células microbianas
más pequeñas, fue Antoni van Leeuwenhoek. Informó de sus investigaciones en una serie de cartas a la prestigiosa Royal Society de Londres, que las publicó en inglés en 1684. -
 Su experimento consistia en hervir caldo de carne para destruir los organismos preexistentes y lo colocó en un recipiente que no estaba debidamente sellado. Al cabo de un tiempo, observó colonias en el recipiente, lo que no contradecía la teoría de la generación espontánea.
Su experimento consistia en hervir caldo de carne para destruir los organismos preexistentes y lo colocó en un recipiente que no estaba debidamente sellado. Al cabo de un tiempo, observó colonias en el recipiente, lo que no contradecía la teoría de la generación espontánea. -
 Repitió los experimentos de Needham. Observo que los microorganismos ingresan desde el aire. Fue una evidencia de que no hay generación espontánea.
Repitió los experimentos de Needham. Observo que los microorganismos ingresan desde el aire. Fue una evidencia de que no hay generación espontánea. -
 Descubrió que la fermentación alcohólica estaba catalizada por microorganismos vivos.Se opuso firmemente a la generación espontánea, esto lo llevo a realizar experimento mediante un matraz de cuello de cisne podía calentar hasta ebullición la solución y esterilizarla.Cuando el matraz se enfriaba, el aire podía entrar, pero la curva en el cuello impedía que la materia particulada entrara en la solución e iniciara la putrefacción.Esto llevo a desarrollos de procedimientos de esterelizacion
Descubrió que la fermentación alcohólica estaba catalizada por microorganismos vivos.Se opuso firmemente a la generación espontánea, esto lo llevo a realizar experimento mediante un matraz de cuello de cisne podía calentar hasta ebullición la solución y esterilizarla.Cuando el matraz se enfriaba, el aire podía entrar, pero la curva en el cuello impedía que la materia particulada entrara en la solución e iniciara la putrefacción.Esto llevo a desarrollos de procedimientos de esterelizacion -
 Cohn describió el ciclo vital de la bacteria formadora de endosporas Bacillus y demostró que las células vegetativas morían al someterlas a ebullición, pero no las endosporas, que eran resistentes. Cohn también sentó las bases de un sistema de clasificación bacteriana, y concibió muchos métodos eficaces para prevenir la contaminación de los medios de cultivo, como el uso del algodón para cerrar tubos y matraces.
Cohn describió el ciclo vital de la bacteria formadora de endosporas Bacillus y demostró que las células vegetativas morían al someterlas a ebullición, pero no las endosporas, que eran resistentes. Cohn también sentó las bases de un sistema de clasificación bacteriana, y concibió muchos métodos eficaces para prevenir la contaminación de los medios de cultivo, como el uso del algodón para cerrar tubos y matraces. -
 Descubrió que la bacteria del carbunco se podía cultivar en caldo nutritivo fuera del hospedador, e incluso después de muchas transferencias de cultivo en laboratorio la bacteria seguía causando la enfermedad al ser inoculada en un animal sano. La importancia de cultivar en el laboratorio Koch formuló un conjunto de criterios rigurosos, conocidos hoy en día como postulados de Koch, que vinculan definitivamente la causa y el efecto en una enfermedad infecciosa
Descubrió que la bacteria del carbunco se podía cultivar en caldo nutritivo fuera del hospedador, e incluso después de muchas transferencias de cultivo en laboratorio la bacteria seguía causando la enfermedad al ser inoculada en un animal sano. La importancia de cultivar en el laboratorio Koch formuló un conjunto de criterios rigurosos, conocidos hoy en día como postulados de Koch, que vinculan definitivamente la causa y el efecto en una enfermedad infecciosa -
Observó las colonias formadas en su cultivo puro que diferían en color y tamaño se perpetuaban.Estas diferencias eran análogas a los criterios que los taxónomos habían establecido para la clasificación de organismos de mayor tamaño, así que sugirió que los diferentes tipos de bacterias deberían ser considerados especies Esto resultó trascendental para la rápida aceptación de la microbiología como nueva ciencia. Otro logro importante fue el descubrimiento del agente causante de la tuberculosis.
Observó las colonias formadas en su cultivo puro que diferían en color y tamaño se perpetuaban.Estas diferencias eran análogas a los criterios que los taxónomos habían establecido para la clasificación de organismos de mayor tamaño, así que sugirió que los diferentes tipos de bacterias deberían ser considerados especies Esto resultó trascendental para la rápida aceptación de la microbiología como nueva ciencia. Otro logro importante fue el descubrimiento del agente causante de la tuberculosis. -
 Algunos de estos logros incluyen el desarrollo de las
Algunos de estos logros incluyen el desarrollo de las
vacunas contra el carbunco, el cólera aviar y la rabia. -
 En 1887, Richard Petri, colaborador de Koch, inventó las placas transparentes de dos caras conocidas como placas de Petri. Este invento se debe al desarrollo de métodos sencillos pero ingeniosos para obtener y cultivar bacterias en cultivo puro.
En 1887, Richard Petri, colaborador de Koch, inventó las placas transparentes de dos caras conocidas como placas de Petri. Este invento se debe al desarrollo de métodos sencillos pero ingeniosos para obtener y cultivar bacterias en cultivo puro. -
 La mayor contribución de Beijerinck al campo de la
La mayor contribución de Beijerinck al campo de la
microbiología fue su clara formulación de la técnica del cultivo
de enriquecimiento.
Otro logro de Beijerinck fue que utilizó filtros selectivos para demostrar que el agente infeccioso de esta enfermedad (un virus) era más pequeño que una bacteria y que, de algún modo, se incorporaba a las células de la hospedadora viva. En este brillante trabajo, Beijerinck no solo describió el primer virus, sino también los principios de la virología. -
 Demostró que bacterias catalizan transformaciones químicas específicas en la naturaleza, y propuso el importante concepto de quimiolitotrofia, la oxidación de compuestos inorgánicos para obtener energía. Además, Winogradsky demostró que estos organismos, a los que llamó quimiolitótrofos, están muy extendidos en la naturaleza y obtienen el carbono del CO2.
Demostró que bacterias catalizan transformaciones químicas específicas en la naturaleza, y propuso el importante concepto de quimiolitotrofia, la oxidación de compuestos inorgánicos para obtener energía. Además, Winogradsky demostró que estos organismos, a los que llamó quimiolitótrofos, están muy extendidos en la naturaleza y obtienen el carbono del CO2.
Winogradsky fue el primero en aislar una bacteria fijadora de nitrógeno.
Plan projects on a visual timeline
Map milestones, phases, deadlines, and key events in one place so the sequence is easier to see and share. Timetoast is a timeline maker for work, school, research, and stories.